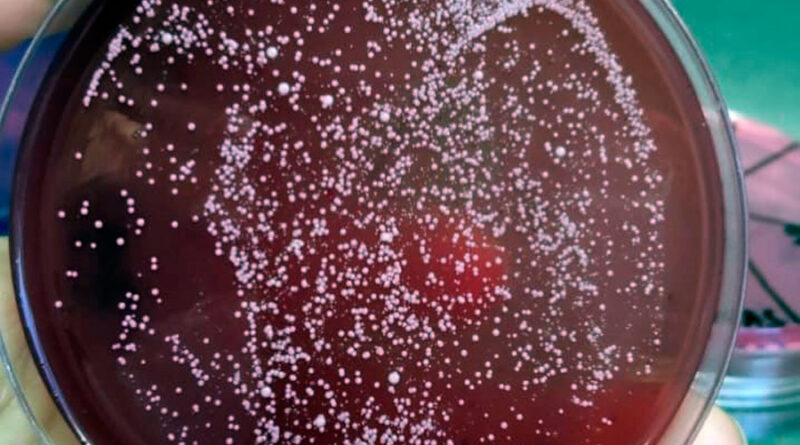

Pesquisa identifica leveduras com potencial para indústria do etanol e da cerveja
Uma pesquisa sobre abelhas sem ferrão no Refúgio Biológico Bela Vista (RBV), mantido pela Itaipu Binacional em Foz do Iguaçu, acaba de render uma descoberta científica no campo da biotecnologia. Pesquisadores identificaram leveduras selvagens capazes de resistir a condições extremas comuns nas indústrias de bioetanol e cervejeira, e que podem impulsionar inovações nesses setores.
A pesquisa faz parte de uma parceria entre a Universidade de São Paulo (USP) e a Itaipu, por meio do Projeto de Conservação das Abelhas sem Ferrão do Refúgio Biológico Bela Vista, e é desenvolvida a partir de amostras de pólen, própolis, mel e cera coletadas diretamente das colônias de abelhas do projeto, em outubro de 2024. O trabalho integra a pesquisa de pós-doutorado de Ana Carolina Souza Ramos de Carvalho, da USP, e busca avaliar o potencial biotecnológico de microrganismos presentes nesse ambiente.
As amostras coletadas resultaram no isolamento de 27 leveduras a partir de 44 coletas. Dessas, 18 espécies foram analisadas quanto à sua capacidade de crescer e fermentar em meios com altas concentrações de sais, simulando os desafios encontrados em processos industriais.

As leveduras são espécies de fungos. Na indústria cervejeira, desempenham um papel crucial para a produção do álcool, dióxido de carbono e diversos compostos que influenciam o aroma, corpo e sabor da bebida. Há diversos tipos de leveduras, como lager (de baixa fermentação, usada em cervejas mais claras e leves) ou ale (de alta fermentação e que resultam em variedades mais encorpadas). As leveduras selvagens, como no caso da identificada pela pesquisa, é usada em cervejas especiais, com características únicas.
“Encontramos uma levedura muito importante dentro do refúgio. Uma Saccharomyces cerevisiae selvagem. Essa levedura é usada há milhares de anos para a produção de alimentos e bebidas, além de também ser amplamente utilizada na indústria de biotecnologia e em pesquisa de base. Mas ainda sabemos pouco sobre seu nicho ecológico”, explicou Carolina. “E encontrar esse tipo de levedura no meio selvagem é um presente”, completou.
Para o sucesso de uma pesquisa como essa, os esforços de conservação empreendidos pela Itaipu no RBV são essenciais. Conforme explica o gestor do projeto, Lucas Tres, da Divisão de Áreas Protegidas da Itaipu, a iniciativa surgiu com o propósito de conservar e valorizar as espécies de abelhas nativas da região, reconhecendo sua importância para a polinização, a manutenção da biodiversidade e a produção de alimentos.
Implantado em 2019, o projeto foi estruturado para unir pesquisa, manejo e educação ambiental. “Com o tempo, o projeto incorporou ações voltadas à formação de multiplicadores, desenvolvendo atividades educativas para visitantes, escolas, universidades e comunidades, além de promover a integração com produtores rurais e instituições de pesquisa”, explicou Lucas.